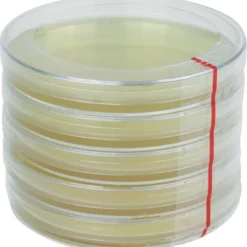
ToshiFarm Petrischaal - 5 Stuks - Petrischalen Met Agar - Steriele Petrischaal Met Agar - Steriele Agar Plaatjes

Aanbieding!
Oorspronkelijke prijs was: 369,00 €.99,99 €Huidige prijs is: 99,99 €.
Aanbieding!
Oorspronkelijke prijs was: 337,00 €.97,99 €Huidige prijs is: 97,99 €.
Aanbieding!
Oorspronkelijke prijs was: 95,50 €.66,85 €Huidige prijs is: 66,85 €.
Aanbieding!
Oorspronkelijke prijs was: 79,85 €.55,90 €Huidige prijs is: 55,90 €.
Aanbieding!
Kweektenten
Oorspronkelijke prijs was: 29,00 €.20,30 €Huidige prijs is: 20,30 €.
Aanbieding!
Oorspronkelijke prijs was: 29,95 €.20,97 €Huidige prijs is: 20,97 €.
Aanbieding!
Kweektenten
Oorspronkelijke prijs was: 64,95 €.45,47 €Huidige prijs is: 45,47 €.
Aanbieding!
Oorspronkelijke prijs was: 16,50 €.11,55 €Huidige prijs is: 11,55 €.